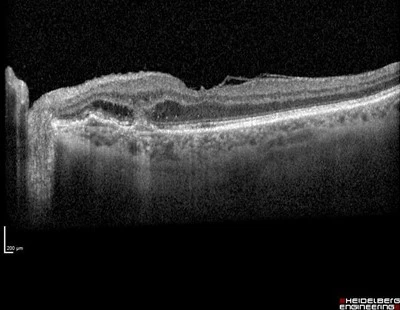
An 84yr old lady was being treated for subretinal new vessel in the right eye. An incidental finding was noticed in the asymptomatic left eye on fundal examination.

March 2025 - 1

Author: Dr Ian Dinihan
An 84yr old lady was being treated for subretinal new vessel in the right eye. Treatment was progressing well and the vision was 6/7.5-1 in the right eye and 6/7.5-2 in the left, having had previous cataract surgery. An incidental finding was noticed in the asymptomatic left eye on fundal examination.
See image above
How should this be managed?
A - Measurement & regular monitoring to assess for growth.
Oops! Try again
B - Fluorescein angiography
Oops! Try again
C - Imaging including B-Scan Ocular Ultrasound and OCT
CORRECT!
D - Wide field fundus photography
Oops! Try again
Answer C
OCT shows a peripapillary sub retinal new vessel-SRNV. Initial examination could confuse this with a choroidal naevus or melanoma.
Careful examination of the photo shows some streaky lipid supertemporal to the macula indicating chronic fluid leakage and membrane activity.
The OCT shows a SRNV with outer retinal fluid and a sub retinal pigment epithelium SRNV expanding into the subretinal space.
The OCT angiogram shows the SRNV clearly, with anastomosing vessels to the choroid seen particularly inferiorly.

Treatment of choice is intravitreal injection of vascular endothelial growth factor inhibitor-anti VEGF- however this is not an approved indication for Medicare rebate. In some cases the anti VEGF medication can be supplied on compassionate grounds by the relevant pharmaceutical company.
The lesion is extrafoveal however laser photocoagulation requires high energy to close the new vessel and has been associated with dramatic decrease in vision as the papillo-macular nerve fibres can be damaged. As mentioned this ladies vision is 6/7.5-2 in this eye. Photodynamic therapy with Verteporfin, PDT, has been used however doses high enough to close the peripapillary new vessel may cause nerve or retinal damage. Other side effects of PDT include secondary SRNV and RPE hyperplasia.
At present Anti VEGF injection is the most effective and safest treatment and can frequency be extended to every three, or possibly four, months but is required long term as the peripapillary SRNV can undergo late reactivation.














